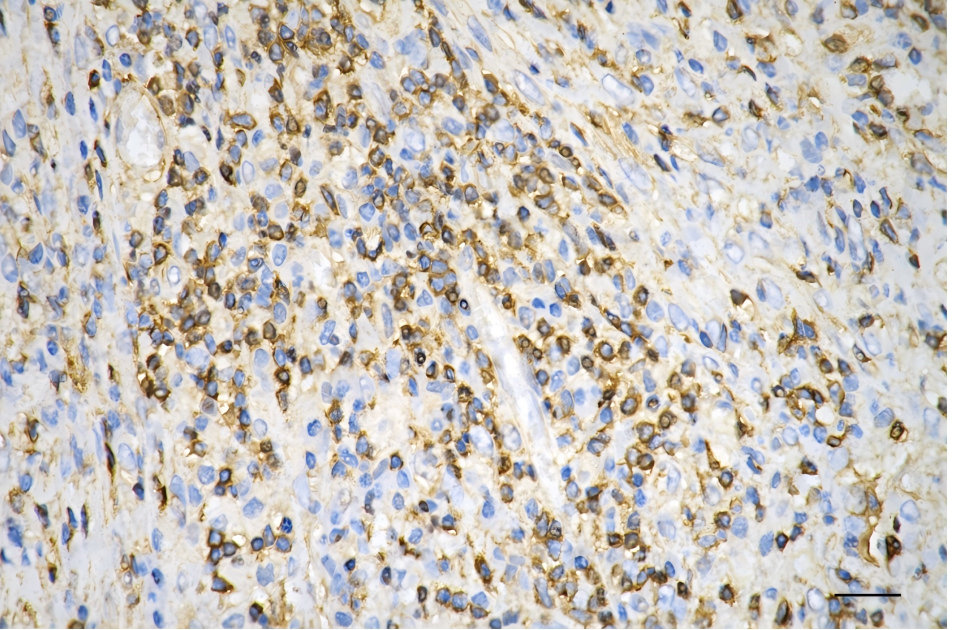

METAP2 Recombinant Monoclonal Antibody
-
中文名稱:METAP2 Recombinant Monoclonal Antibody
-
貨號:CSB-RA253256A0HU
-
規(guī)格:¥1320
-
圖片:
-
Flow cytometric analysis of methionyl aminopeptidase 2 expression in HepG2 cells using methionyl aminopeptidase 2 antibody. Green, isotype control; red, methionyl aminopeptidase 2.
-
Immunocytochemical staining of HepG2 cells with Methionyl aminopeptidase 2 antibody. Nuclei were stained blue with DAPI; Methionyl aminopeptidase 2 was stained magenta with Alexa Fluor? 647. Images were taken using Leica stellaris 5. Protein abundance based on laser Intensity and smart gain: Medium. Scale bar, 20 μm.
-
Immunohistochemistry was performed on paraffin-embedded human sigmoid colon carcinoma using methionyl aminopeptidase 2 antibody. Antigen retrieval was done in sodium citrate buffer (pH 6.0). DAB was used for detection, with hematoxylin counterstaining. Images were acquired using a Nikon Ci-L Plus microscope (40× objective). Scale bar: 25 μm.
-
Western blotting analysis using methionyl aminopeptidase 2 antibody. Total cell lysates (30 μg) from various cell lines were loaded and separated by SDS-PAGE. The blot was incubated with methionyl aminopeptidase 2 antibody and HRP-conjugated goat anti-rabbit secondary antibody respectively.
-
-
其他:
產(chǎn)品詳情
-
Uniprot No.:
-
基因名:
-
別名:METAP2; Methionyl Aminopeptidase 2; MNPEP; MAP2; P67; Initiation Factor 2-Associated 67 KDa Glycoprotein; Methionine Aminopeptidase 2; Peptidase M; P67eIF2; Testicular Tissue Protein Li 17; EIF-2-Associated P67 Homolog; Peptidase M 2; EC 3.4.11.18; P67EIF2; MetAP 2; MAP 2
-
反應種屬:Human, Mouse, Rat
-
免疫原:A synthesized peptide derived from Human METAP2 protein
-
免疫原種屬:Homo sapiens (Human)
-
標記方式:Non-conjugated
-
克隆類型:Monoclonal
-
抗體亞型:Rabbit IgG
-
純化方式:Affinity-chromatography
-
克隆號:6G9
-
濃度:It differs from different batches. Please contact us to confirm it.
-
保存緩沖液:Rabbit IgG in PBS (pH 7.4) containing 50% glycerol, and 0.02% sodium azide.
-
產(chǎn)品提供形式:Liquid
-
應用范圍:ELISA, WB, FC, ICC, IHC
-
推薦稀釋比:
Application Recommended Dilution WB 1:1000-1:5000 FC 1:200-1:2000 ICC 1:100-1:1000 IHC 1:100-1:200 -
Protocols:
-
儲存條件:Upon receipt, store at -20°C or -80°C. Avoid repeated freeze.
-
貨期:Basically, we can dispatch the products out in 1-3 working days after receiving your orders. Delivery time maybe differs from different purchasing way or location, please kindly consult your local distributors for specific delivery time.
-
用途:For Research Use Only. Not for use in diagnostic or therapeutic procedures.
相關產(chǎn)品
靶點詳情
-
功能:Cotranslationally removes the N-terminal methionine from nascent proteins. The N-terminal methionine is often cleaved when the second residue in the primary sequence is small and uncharged (Met-Ala-, Cys, Gly, Pro, Ser, Thr, or Val). The catalytic activity of human METAP2 toward Met-Val peptides is consistently two orders of magnitude higher than that of METAP1, suggesting that it is responsible for processing proteins containing N-terminal Met-Val and Met-Thr sequences in vivo.; Protects eukaryotic initiation factor EIF2S1 from translation-inhibiting phosphorylation by inhibitory kinases such as EIF2AK2/PKR and EIF2AK1/HCR. Plays a critical role in the regulation of protein synthesis.
-
基因功能參考文獻:
- MetAP1 and MetAP2 have roles in driving cell selectivity for a potent anti-cancer agent in synergy, by controlling glutathione redox state PMID: 27542228
- Suggest MetAP2 as important regulator of proliferation/apoptosis in non-small cell lung cancers. PMID: 26935506
- Nt-acetylation prevents the excision of the initiator methionine by MetAP2. PMID: 25886145
- Data indicate that methionine aminopeptidase 2 (MetAP2) contains a single disulfide bond that exists in oxidized and reduced states and influences enzyme function. PMID: 24700462
- The activity of unmodified, nitrated and oxidised METAP2 was assessed and it was found that nitration significantly reduced its ability to cleave a chromogenic substrate. Mass spectrometry analysis identified Tyr336 as a nitrated residue in METAP2. PMID: 24041691
- Increased expression of METAP2 is associated with pilocytic astrocytoma. PMID: 23161775
- This study demonstrated a hitherto-undescribed role of MetAP2 in definitive hematopoiesis and a possible link to noncanonical Wnt and ERK signaling. PMID: 21937698
- the substrate specificities of Escherichia coli MetAP1, human MetAP1, and human MetAP2 were systematically profiled PMID: 20521764
- Data indicate that MetAP2 expression and pp60c-src phosphorylation were decreased in NC2213 treated cells. PMID: 19703310
- the functional role of S100A4 in regulating endothelial cell growth and tumor metastasis involves interaction with the N-terminal half of Methionine Aminopeptidase 2. PMID: 11994292
- High expression in germinal center B cells and their neoplastic counterparts. PMID: 12118091
- Divalent metal cofactors are physiologically relevant for activity of this enzyme. PMID: 12718546
- MetAP protein has a role in colorectal adenocarcinoma progression PMID: 15102683
- Expressed in colon cancer cells PMID: 15336565
- MetAP-1 and MetAP-2 have essential functions in the control of mammalian cell proliferation PMID: 15962312
- A comparison of the structual differences between Type I and Type II methionine aminopeptidases. PMID: 16274222
- Data suggest that methionine aminopeptidase 2 plays a role in the proliferation of fibroblasts and myofibroblasts in fibrotic lung diseases and may serve as a novel pharmacologic target in idiopathic pulmonary fibrosis. PMID: 17446530
- MetAP2 plays an important role in tumor cell growth and may contribute to tumorigenesis PMID: 18264137
- Discovery, identification, and characterization of candidate pharmacodynamic markers of METAP2 inhibition are reported. PMID: 18828628
- Using bovine cell extract, fumagillin was found to be bound by methionine aminopeptidase (MetAP-2). PMID: 9177176
顯示更多
收起更多
-
亞細胞定位:Cytoplasm. Note=About 30% of expressed METAP2 associates with polysomes.
-
蛋白家族:Peptidase M24A family, Methionine aminopeptidase eukaryotic type 2 subfamily
-
數(shù)據(jù)庫鏈接:
Most popular with customers
-
-
YWHAB Recombinant Monoclonal Antibody
Applications: ELISA, WB, IHC, IF, FC
Species Reactivity: Human, Mouse, Rat
-
Phospho-YAP1 (S127) Recombinant Monoclonal Antibody
Applications: ELISA, WB, IHC
Species Reactivity: Human
-
-
-
-
-